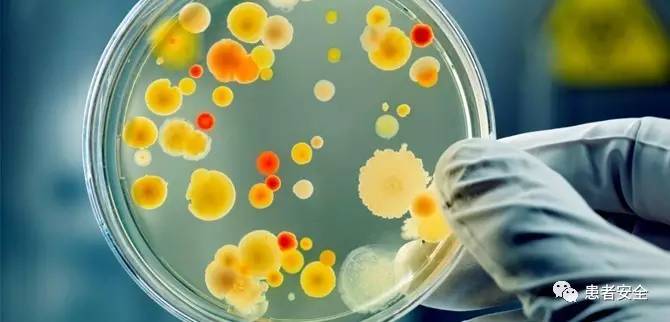
美国最严重的安全事故,美国十大安全事故

10 top patient safety issues for 2017
编译自:Heather Punke & Brian Zimmerman, BECLER’S Infection Control& Clinical Quality,January 18, 2017 图片来自网络

贝克尔的医疗保健(Becker'sHealthcare)是美国高端医疗行业领袖们主要的商业和法律参考信息来源。贝克尔感染控制与临床质量(Becker's Infection Control & Clinical Quality)是五大板块之一,该编辑团队选择以下10个患者安全议题作为2017年医疗服务提供者优先考虑的问题。
医疗卫生公平性(Health equity)
2001年,美国医学研究所(Institute of Medicine)发布了提高卫生保健的六个目标:安全、有效、以患者为中心、及时、高效和公平。美国医疗改进研究所(Institute forHealthcare Improvement,IHI)称前五个目标已经取得了较大的进展,而医疗公平性方面却迟迟未有进展。IHI在2016年的白皮书中将医疗卫生公平性称之为“被遗忘了的目标”。
IHI将医疗卫生公平性定义为“每个人都有获得全面卫生保健资源的机会”。当卫生保健资源不公平时,将给患者带来不利的医疗后果。例如,在美国黑人的平均寿命相对于白人低得多,收入低的家庭相对于收入高的家庭有更高的死亡风险。
社会因素在医疗卫生方面扮演着重要的角色,而医疗卫生机构对于改善医疗服务公平性也承担着很大的责任。IHI、CDC和其他组织开发了一些可用的资源,让医院和医师学习如何将医疗卫生公平性放到战略性的首要地位、如何降低制度性种族歧视以及如何与社区的其他组织机构合作。

抗生素耐药性增长 (Growth of antibiotic resistance )
细菌和真菌对抗生素的抵抗力在持续不断地增加,即使是最后一道防线的抗生素如碳青霉烯和粘菌素也如此。在5月份,美国疾控中心(CDC)Tom Frieden主任向华盛顿邮报透露:“抗生素的尽头已经不远了,我们可能即将处于这样的处境,重症监护室的患者或尿路感染的患者将没有有效的抗生素可用。”
医院方面应该实施抗生素管理项目来阻止抗生素耐药性的增长。在5月份,CDC和美国质量论坛(National Quality Forum)发布了“急性医疗照护的抗生素管理:实用指南”,旨在帮助医院设立这样的管理项目,此举对于阻止抗生素耐药性的增长至关重要,因此,美国医疗机构评审联合委员会(TJC)将抗生素管理标准纳入了2017年的认证程序中。

医疗照护转换中信息传递问题(Patient care transitions)
患者交接总是一个有风险的时刻,不论是从一个医疗组交接到另一个医疗组,还是从急性护理转到急性后期护理或者家里。在12月,美国医学杂志(JAMA)发布了的一项研究进一步证实了这一事实,医疗组之间的交接与住院患者的高风险死亡率有很大的关系。
幸运的是,已经有了一些患者交接工具和清单来强化这一过程,对使用这些交接协议的分析研究在11月的《人因工程和人体工程学协会杂志》上发表,证明这些方法确实有用。“不管环境或者协议的类型如何,使用患者交接协议,确凿证据表明总体效果良好。”

消毒和再处理问题(Sterilization and reprocessing issues)
消毒处理部门的问题会让患者遭受由手术器械和医疗设备带来的各种感染风险。2016年,医院和诊所仍然遇到了很多可重复使用的医疗器械的清洗、再处理或消毒的问题。
一些挑战来自于器械的设计。例如,2016年10月《感染控制和医院流行病学杂志》(InfectionControl & Hospital Epidemiology)上的一项研究发现,完全清除机器人手术器械的所有污染物几乎是不可能的。同样,专家称与多重耐药菌爆发相关的十二指肠镜也几乎不可能完全清洗干净。
其他问题是消毒处理部门的员工缺乏培训。例如,2016年秋季,底特律医疗中心的一项全美调查发现对于主要的消毒处理人员缺乏一个“稳定的、持续的、可重复的、全面记录的和维护良好的培训系统”是导致手术病人遭受感染风险的诸多问题之一。医院可以改善这一问题,确保员工正确接受最新的消毒流程培训,确保员工遵照制造商的清洗说明,并将说明书制作得尽可能地简单明了。

质量相关数据的透明性(Quality data transparency)
2016年,CMS推行了饱受争议的医院整体质量星级评定项目,根据医院的表现给予1-5星的评定。CMS认为这种评定方式可以“帮助数百万的患者和他们的家人了解医院的整体水平,比较他们区域的医疗设施以及询问关于医疗质量的重要问题。”
然而,这种星级评定受到了一些指责。一些利益相关者认为CMS项目有缺陷,包括风险系数不恰当,使得诊治病情相对更复杂的大型医院不太可能获得较高的星级评定。
其他评论家将CMS星级评定视为在本来都相互冲突的排名和评价体系中增加了一种说法。在11月的JAMA,有一种观点指出“所有评价医院‘好’或‘坏’的评级体系都没有达成共识。医院评级体系提供了相互矛盾的信息,它们很少就哪个医院的表现好和哪个医院表现差拥有一致的意见。”
一些机构已经将质量数据的透明度掌握在了自己的手中。例如,美国新泽西州Meridian Health在自己医院的网站上发布业绩报告,这样患者就能看到目前的数据,并与此区域的其他医疗机构相比较。
哈肯萨克市Meridian Health质量办公室副主任Marty Scott在一次Becker's 的采访中讲到:“我们相信我们会拥有一套评价系统,并将其设计成易于人们理解的格式,并且数据更及时。”

水质污染问题(Contaminated water)
2016年,医院面临着很多与污染水体相关的患者安全挑战。军团菌属细菌的传播,会引发一种类型的肺炎,这个问题尤其突出。例如,在9月,西雅图华盛顿大学医学中心的5位患者感染了军团病,其中2位患者死亡。细菌感染可能是导致死亡的原因。随后的调查发现在医学中心心脏病房的制冰机和两个水槽里检测出了军团菌属细菌。
在10月,STAT调查了医院设置更多水槽的意外后果。本来安装水槽是为了做到更好的手卫生,但是水槽的喷洒可能会使受到污染的水滴成烟雾状散开,从而使附近的患者受到感染。文章列举了若干例与医院水槽相关的患者感染。荷兰发生了1例类似事件后,医院将病房里的所有水槽拆除了以阻止细菌的传播。
为了避免类似事件发生,多伦多大学健康网络感染控制部门主任Michael Gardam建议,“不要使用鹅脖子型(Gooseneck)水龙头直接排放到下水管;使水从洗手池的边缘排出去;不允许水龙头喷洒式出水。确保水槽足够深,以至于不会让水溅到人身上和衣服。确保水槽周围的物质是防水的。

疫苗覆盖率问题(Vaccine coverage)
2016年,不严格遵从疫苗接种程序表导致了可预防性疾病的爆发。根据CDC报道,多起流行性腮腺炎的爆发使得病毒复苏,并达到了10年来的最高值。12月3日,46个州和华盛顿特区共报道了4258例流行性腮腺炎。
流行性感冒同样在很大程度上可以通过疫苗预防,但是很少的美国人接种了此疫苗。2015年,流感疫苗预防了估计500万例疾病以及7万多例住院治疗。但是,2016年接种此类预防潜在致死病毒的疫苗的人数比例仍然较低。大约五个美国人中有两人接种了流感疫苗,跟2015年的比例差不多。
CDC国家免疫和呼吸道疾病中心主任Nancy Messonnier讲到:“我们有预防流感病毒的手段,但是成千上万的人却没有利用。太多的人没有受到保护。”
尽管关于疫苗的不实报道仍然层出不穷,但是医疗保健组织必须保持高度的警惕性,要在2017年对患者和患者家人做好关于疫苗保护作用的教育工作。

行为健康管理问题(Behavioral health management protocols)
当患者患精神疾病或由于滥用药物被送入急诊室,这样的经历对于患者和医疗服务提供者都是难受的,而且这些遭遇有时会积累走向*力暴**倾向。
2016年,纽约时报报道了在休斯顿圣约瑟夫医疗中心一名患者被枪击的事件。Alan Pean是双相患者,经历着精神上的痛苦,住院以来,反复全身赤裸在病房走廊上行走,工作人员将其引回病房。据称患者没有攻击性和威胁性,但是护士给他穿好长袍后,他拒绝拴好衣服。护士根据医院的流程,通知了休斯顿警察局提供安全保障。当警员到达Pean先生的病房后,并关上了门,经过一番争斗之后,Pean先生被枪击,并给他戴上了*铐手**。
这个案例掀起了关于医院配备武装警卫人员的必要性和安全性的激烈争论。纽约时报引用了约翰霍普金斯医学院急救医学部主任Gabor Kelen的一项研究。该项研究发现所有的急救部门枪击事件中,23%都与医院警卫人员的枪被偷有关。
医院管理者要确保医院警卫人员训练有素,足以应对意识不清或激进患者带来的危险,只有这样才能在如此环境下保护好医疗机构和患者安全。

导尿管相关性尿路感染(Catheter-associated urinary tract infections)
12月5日,CDC's Winnable Battles计划发布了一份报告,指出在降低医院获得性感染方面取得了很大的进步,但有一个例外:导尿管相关尿路感染(CAUTIs)。尽管之前的研究表明69%的导尿管相关尿路感染是可以预防的,但是其感染一直是困扰医院的一大问题。
CDC于2010年开始施行Winnable Battles计划,并且树立了2015年完成的远大目标。结果显示降低60%中央静脉导管相关性血液感染和侵入性耐甲氧西林金黄色葡萄球菌感染的目标已经在实现的路上了,降低30%手术部位感染的目标看来也可能实现。然而,降低30%急性照护医院的导尿管相关尿路感染的目标却没有达到。CDC的数据说明了病房的导尿管相关尿路感染降低了24%,重症监护室的导尿管相关的尿路感染却增加了16%。
不过,一项由美国卫生保健研究署(AHRQ)支持的降低导尿管相关尿路感染合作计划的有效性通过审查,是很有希望的。此项行动为603所医院的医生、护士提供降低CAUTI的质量综合单元安全程序工具包。遵从计划的结果是普通病房的CAUTIs降低了近1/3。

新兴疾病 / 新的疾病爆发(Emerging diseases / new outbreaks)
2016年寨卡病毒(Zika)得到了大众和传染病专家的关注。11月30日,据CDC统计美国有1172名孕妇感染了寨卡病毒,导致了32名婴儿先天畸形,另有5名先天畸形的胎儿还未出生就夭折了。
在10月,CDC主任Frieden博士将寨卡病毒这样的病原体传播描述成是全球化旅游和贸易、高密度大都市和气候变化时代的一种“新的正常现象”。
像2016年的寨卡病毒和2014年的埃博拉病毒(Ebola),这样的新兴疾病将会是医院持续面临的问题,因为针对这些病毒的疫苗还没有研制出来。传染病专家应该竭尽所能地认识到马雅罗病毒(Mayaro)、里夫特裂谷热(Rift Valley)或黑苏图黄病毒(Usutu)这类的新兴病毒,以防未来引起病毒爆发。
2017年需要警惕的是致命的酵母菌感染,2016年首次在美国出现,迄今已有19人感染。CDC估计未来会有更多的人感染。酵母菌病毒的一些菌株,如被称之为c .奥瑞丝(auris)的病毒,已经对三种主要的抗真菌药物形成了耐药性。致命的酵母菌已经在几大洲的很多国家的医疗机构引发了病毒爆发。

【原文】
翻译:陈秋霞 重庆医科大学附属第一医院设备处
审校:肖明朝 重庆医科大学附属第一医院泌尿外科